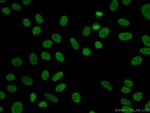
YY1 Antibody in Immunocytochemistry (ICC/IF)

Search
Proteintech
YY1 Polyclonal Antibody
{{$productOrderCtrl.translations['antibody.pdp.commerceCard.promotion.promotions']}}
{{$productOrderCtrl.translations['antibody.pdp.commerceCard.promotion.viewpromo']}}
{{$productOrderCtrl.translations['antibody.pdp.commerceCard.promotion.promocode']}}: {{promo.promoCode}} {{promo.promoTitle}} {{promo.promoDescription}}. {{$productOrderCtrl.translations['antibody.pdp.commerceCard.promotion.learnmore']}}
产品信息
22156-1-AP
种属反应
已发表种属
宿主/亚型
分类
类型
抗原
偶联物
形式
浓度
规格
纯化类型
保存液
内含物
保存条件
运输条件
产品详细信息
The open reading frame of the human YY1 cDNA encodes a protein of 414 amino acids with a predicted molecular weight of 44 kDa. However, YY1 migrates on SDS gels as a 65-68 kDa protein, probably due to the structure of the protein. It is a ubiquitously expressed transcription factor with fundamental roles in embryogenesis, differentiation, replication, and proliferation. This is a rabbit polyclonal antibody raised against full length YY1 of human origin.
Immunogen sequence: MASGDTLYI ATDGSEMPAE IVELHEIEVE TIPVETIETT VVGEEEEEDD DDEDGGGGDH GGGGGHGHAG HHHHHHHHHH HPPMIALQPL VTDDPTQVHH HQEVILVQTR EEVVGGDDSD GLRAEDGFED QILIPVPAPA GGDDDYIEQT LVTVAAAGKS GGGGSSSSGG GRVKKGGGKK SGKKSYLSGG AGAAGGGGAD PGNKKWEQKQ VQIKTLEGEF SVTMWSSDEK KDIDHETVVE EQIIGENSPP DYSEYMTGKK LPPGGIPGID LSDPKQLAEF ARMKPRKIKE DDAPRTIACP HKGCTKMFRD NSAMRKHLHT HGPRVHVCAE CGKAFVESSK LKRHQLVHTG EKPFQCTFEG CGKRFSLDFN LRTHVRIHTG DRPYVCPFDG CNKKFAQSTN LKSHILTHAK AKNNQ (1-414 aa encoded by BC037308)
靶标信息
YY1 is a ubiquitously distributed transcription factor belonging to the GLI-Kruppel class of zinc finger proteins. The protein is involved in repressing and activating a diverse number of promoters. YY1 may direct histone deacetylases and histone acetyltransferases to a promoter in order to activate or repress the promoter, thus implicating histone modification in the function of YY1.
仅用于科研。不用于诊断过程。未经明确授权不得转售。
生物信息学
蛋白别名: Delta transcription factor; INO80 complex subunit S; NF-E1; Transcriptional repressor protein YY1; UCR-motif DNA-binding protein; UCRBP transcription factor; Yin and yang 1; Yin and Yang 1 protein; Yin Yang 1; YY-1
基因别名: AW488674; DELTA; GADEVS; INO80S; NF-E1; UCRBP; YIN-YANG-1; YY1
UniProt ID: (Human) P25490, (Mouse) Q00899
Entrez Gene ID: (Human) 7528, (Mouse) 22632